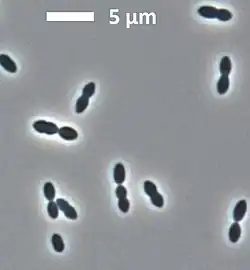

Blautia caecimuris
Blautia caecimuris es una bacteria grampositiva del género Blautia. Fue descrita en el año 2016. Su etimología hace referencia al intestino ciego de un ratón.[1] Es anaerobia estricta. Las células tienen forma ovalada. Temperatura de crecimiento de 37 °C. Tiene un contenido de G+C de 43%. Se ha aislado del intestino de un ratón en Alemania.
| Blautia caecimuris | ||
|---|---|---|
![]() | ||
| Taxonomía | ||
| Dominio: | Bacteria | |
| Filo: | Bacillota | |
| Clase: | Clostridia | |
| Orden: | Eubacteriales | |
| Familia: | Lachnospiraceae | |
| Género: | Blautia | |
| Especie: | Blautia caecimuris | |
Referencias
- Lagkouvardos, Ilias; Pukall, Rüdiger; Abt, Birte; Foesel, Bärbel U.; Meier-Kolthoff, Jan P.; Kumar, Neeraj; Bresciani, Anne; Martínez, Inés et al. (8 de agosto de 2016). «The Mouse Intestinal Bacterial Collection (miBC) provides host-specific insight into cultured diversity and functional potential of the gut microbiota». Nature Microbiology 1 (10): 16131. ISSN 2058-5276. PMID 27670113. doi:10.1038/nmicrobiol.2016.131. Consultado el 10 de septiembre de 2022.
Este artículo ha sido escrito por Wikipedia. El texto está disponible bajo la licencia Creative Commons - Atribución - CompartirIgual. Pueden aplicarse cláusulas adicionales a los archivos multimedia.